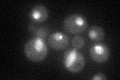
YFL008W
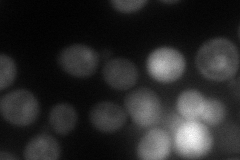
YFL008W
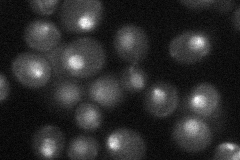
YFL008W
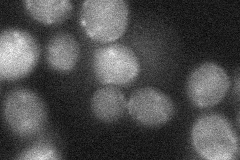
YFL008W
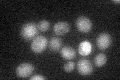
YFL008W

View description
Subunit of the multiprotein cohesin complex, essential protein involved in chromosome segregation and in double-strand DNA break repair; SMC chromosomal ATPase family member, binds DNA with a preference for DNA with secondary structure
Localization:
Intensity:
Fold change:
Significance:
-
C’ GFP library in SD
nucleus36.51 -
N' NOP1pr-GFP in SD

cytosol,nucleus75.8957 -
N' TEF2pr-mCherry in SD
nucleolus53.3484 -
N' NATIVEpr-GFP in SD
punctate,nucleus36.7127 -
N' TEF2pr-VC and Cyto-VN in SD
below threshold27.2731 -
C’ GFP library in SD+DTT

nucleus37.841.03No -
C’ GFP library in SD+H2O2

nucleus46.271.26No -
C’ GFP library in Starvation Media
nucleus32.180.88No -
C’ GFP library on the background of Pup2-DaMP

nucleus -
C’ GFP library on the background of CCT mutant

nucleus40.33711.10436No
